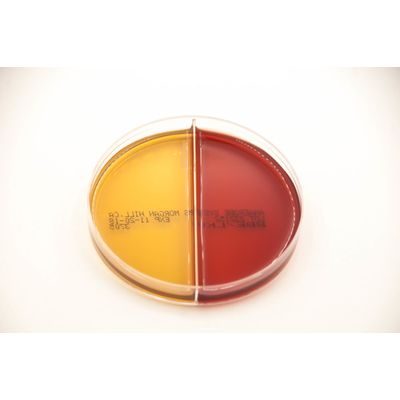

- Home
- Companies
- Anaerobe Systems
- Products
- Anaerobe Systems - Model BBE/LKV - ...
Anaerobe Systems - Model BBE/LKV -Bacteroides Bile Esculin and Laked Kanamycin Vancomycin Bi-Plate
BBE: Bacteroides Bile Esculin (BBE) agar is an enriched, selective, and differential medium used for the isolation and presumptive identification of obligately anaerobic gram-negative bacilli of the Bacteroides fragilis group and Bilophila wadsworthia (4). LKV: Laked Brucella Blood Agar with Kanamycin and Vancomycin (LKV) is an enriched, selective, and differential medium for the isolation and partial identification of obligately anaerobic gram-negative bacilli. LKV agar is useful for the rapid isolation of Prevotella species.
Bacteroides Bile Esculin (BBE) agar is an enriched, selective, and differential medium used for the isolation and presumptive identification of obligately anaerobic gram-negative bacilli of the Bacteroides fragilis group and Bilophila wadsworthia (4).
If used properly, BBE agar supports good growth of the Bacteroides fragilis group (B. fragilis, B. distasonis, B. thetaiotaomicron, B. ovatus, and B. vulgatus) and inhibits growth of most facultative anaerobes and most other non-Bacteroides obligately anaerobic bacteria. Members of the B. fragilis group should grow as brown to black colonies surrounded by a brown to black zone in the media, except for B. ovatus and B. vulgatus, which produce catalase.
BBE agar will not provide complete information for identification of bacterial isolates. Additional test procedures and media are required for complete identification. Some organisms that would normally grow on BBE medium may be inhibited. It is recommended that a non-selective medium, such as Brucella Blood Agar (BRU, catalog #: AS-111) also be inoculated from the same clinical specimen to assure recovery of all species present. Some strains of facultative organisms (which should be inhibited) may grow on BBE. A test for aerotolerance should be performed to confirm that each colony type is an obligate anaerobe. Consult reference materials for additional information.
The following organisms are routinely used for quality control testing at Anaerobe Systems.
| Organism Tested | ATCC # | Results | Time | Special Reaction |
| Bacteroides fragilis* | 25285 | Growth | 24 hrs | |
| Prevotella melaninogenica* | 25845 | Growth | 24 – 48 hrs | Pigmentt (tan color) |
| Fusobacterium necrophorum | 25286 | Growth | 24 hrs | |
| Fusobacterium nucleatum* | 25586 | Growth | 24 hrs | |
| Clostridium perfringens* | 13124 | Growth | 24 hrs | Double Zone of β-hemolysis |
| Peptostreptococcus anaerobius* | 27337 | Growth | 24 hrs | |
| Staphylococcus aureus or Enterococcus faecalis | 25923 29212 | Growth | 24 hrs | |
| Escherichia coli | 25922 | Growth | 24 hrs | |
| Proteus mirabilis | 12453 | Growth | 24 hrs | |
| Propionibacterium acnes or Clostridium difficile | 6919 9689 | Growth | 24 – 48 hrs
24 hrs |
LKV Storage: Upon receipt, store at room temperature in original package until used. Avoid overheating or freezing. Do not use media if there are signs of deterioration (shrinking, cracking, or discoloration due to oxidation of media) or contamination. The expiration date applies to the product in its original packaging and stored as directed. Do not use product past the expiration date shown on the label.
LKV Shelf Life: 90 days from date of manufacture.
